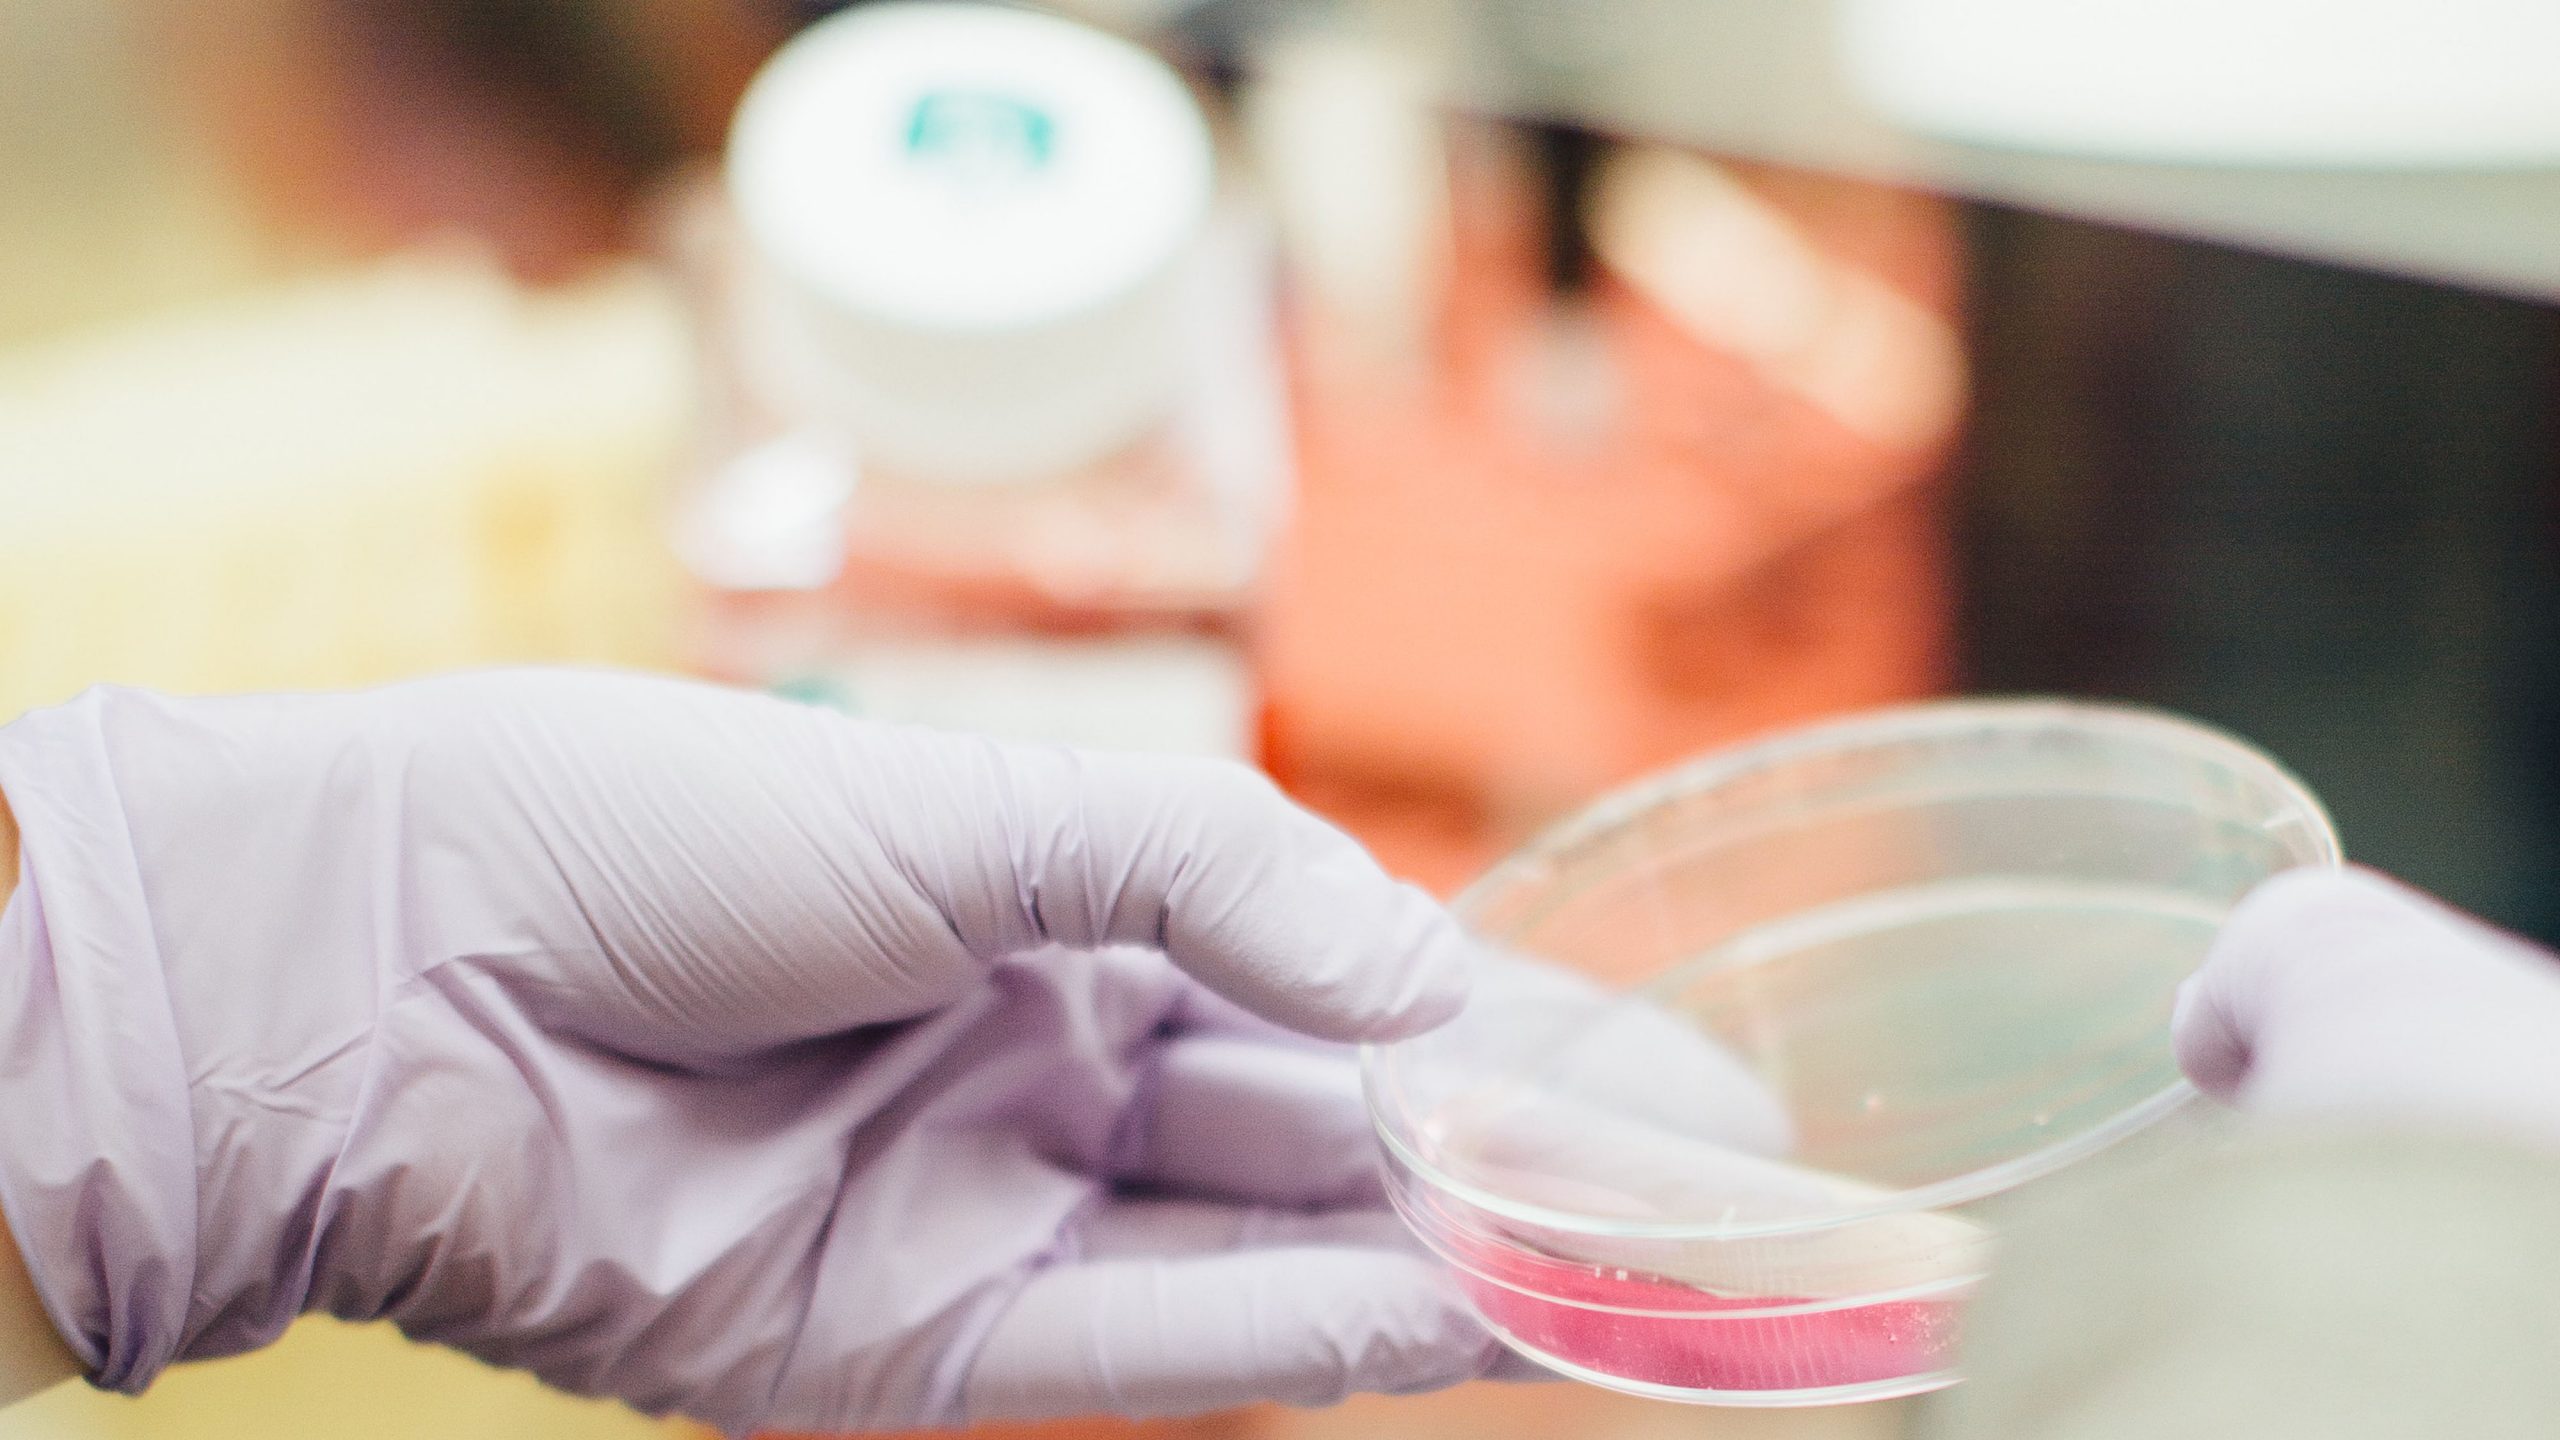

Claus Stig Pedersen, direktør for bæredygtighed hos Novozymes er key note på Open Entreprenuerships konference
14 July 2021. By David Erichsen. Det er mødet og relationen mellem forskere og intraprenører, som er helt centralt for Open Entrepreneurship. Derfor har fokus i første halvår af 2021 også været at etablere systematiske netværksmøder, hvor e-korpset – det landsdækkende korps af entreprenører og intraprenører – løbende præsenteres for forskernes cases. I 2021 er …
2 June 2021. By David Erichsen. I den kommende tid vil Copenhagen Solutions Lab, Kriminalforsorgen, STAYRELEVANT-IT, Danmarks Tekniske Museum, Københavns Professionshøjskole mf. blive inviteret til de første aktiviteter i Center for Digital Velfærd, hvor de sammen med de tilknyttede forskere vil udveksle viden og erfaringer ifm. digitaliseringen af vores velfærdssamfund. Tematiserede arbejdsgrupper Aktiviteterne er centreret …
18 May 2021. By David Erichsen. At der ikke er en modsætning mellem erhvervssamarbejde og topforskning, er en vigtig pointe, som innovationsdirektør, Dorte Maarbjerg Stigaard, og rektor Per Michael Johansen fra Aalborg Universitet, beskriver i et debatindlæg på Altingets forskningsportal. De mener, at et universitet både kan levere forskning i verdensklasse og samarbejde med virksomheder …
4 May 2021. By David Erichsen. Open Entrepreneurship tilstræber balance mellem mænd og kvinder i arbejdet med at skabe nye virksomheder med afsæt i forskning. Nu er turen kommet til det eksterne netværk – e-korpset Organisatorisk består Open Entrepreneurship af en central hub forankret på DTU og en række selvstændige enheder på landets universiteter, som …
16 April 2021. Open Entrepreneurship er en gennemprøvet og velfungerende infrastruktur, som effektivt kobler forskning på tværs af landets universiteter med virksomheder og iværksættere. En infrastruktur og særlig tilgang til innovations- og entreprenørskabsprojekter i spændingsfeltet mellem forskning og erhvervsliv, som fremover bliver en integreret del af regeringens nye strategi for at løfte dansk life science …
30 March 2021. Artikel fra DTUs magasin Dynamo af Christina Tækker. Erfarne entreprenører skaber nye virksomheder med forskere fra landets universiteter i et prisbelønnet iværksætterprojekt. Det har indtil nu ført til etableringen af 26 nye virksomheder. Ambitionen med Open Entrepreneurship er at udvikle og afprøve en ny samarbejdsmodel, der skal øge evnen til at kommercialisere …
25 January 2021. By David Erichsen In 2021, Open Entrepreneurship launches a new concept of matchmaking meetings where the members of Open Entrepreneurship’s e-corps community will be introduced to spin out cases and meet researchers behind them. The first meeting will be on Wednesday 27 January Open Entrepreneurship kicks off 2021 with its first network …
5 January 2021 In November 2020, Open Entrepreneurship won in the category “Promoting the entrepreneurial spirit” at the European Enterprise Promotion Awards at the EU commission’s SME assembly. The EU commission’s SME assembly is the most significant event for small and medium-sized enterprises (SMEs) in Europe and home to the European Enterprise Promotion Awards. Based …
1 December 2020. Af Helle Nielsen-Elgaard, Innovationschef, Open Entrepreneurship, Jes Broeng, Centerleder, DTU Entrepreneurship & Programleder Open Entrepreneuship og Marianne Thellersen Koncerndirektør for Innovation og Entrepreneurskab på DTU. Innovationsfonden skal fremover i højere grad bidrage til løsning af grøn omstilling og andre store samfundsudfordringer, og udfordringerne skal i højere grad besluttes fra politisk hold. Det …